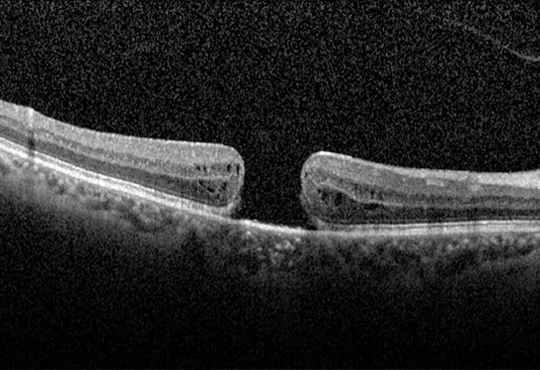
retinosis pigmentaria

AMBLIOPÍA
Es la pérdida de la capacidad para ver claramente a través de un ojo. También se denomina "ojo perezoso". Es la causa más común de problemas de visión en los niños que generalmente se debe a problemas refractivos. El oftalmólogo buscará diagnosticar y corregir, primeramente, la causa de la ambliopía; después tratará la ambliopía con la ayuda del niño quien deberá esforzarse en usar su ojo “vago”. Esto se logra cubriendo con un parche el ojo con buena visión durante el día, y en determinados horarios, por semanas o meses. El resultado del tratamiento dependerá de la severidad de la ambliopía y de la edad del niño al momento de la detección por eso es muy importante hacer visitas con el oftalmólogo desde temprana edad.
Compartir